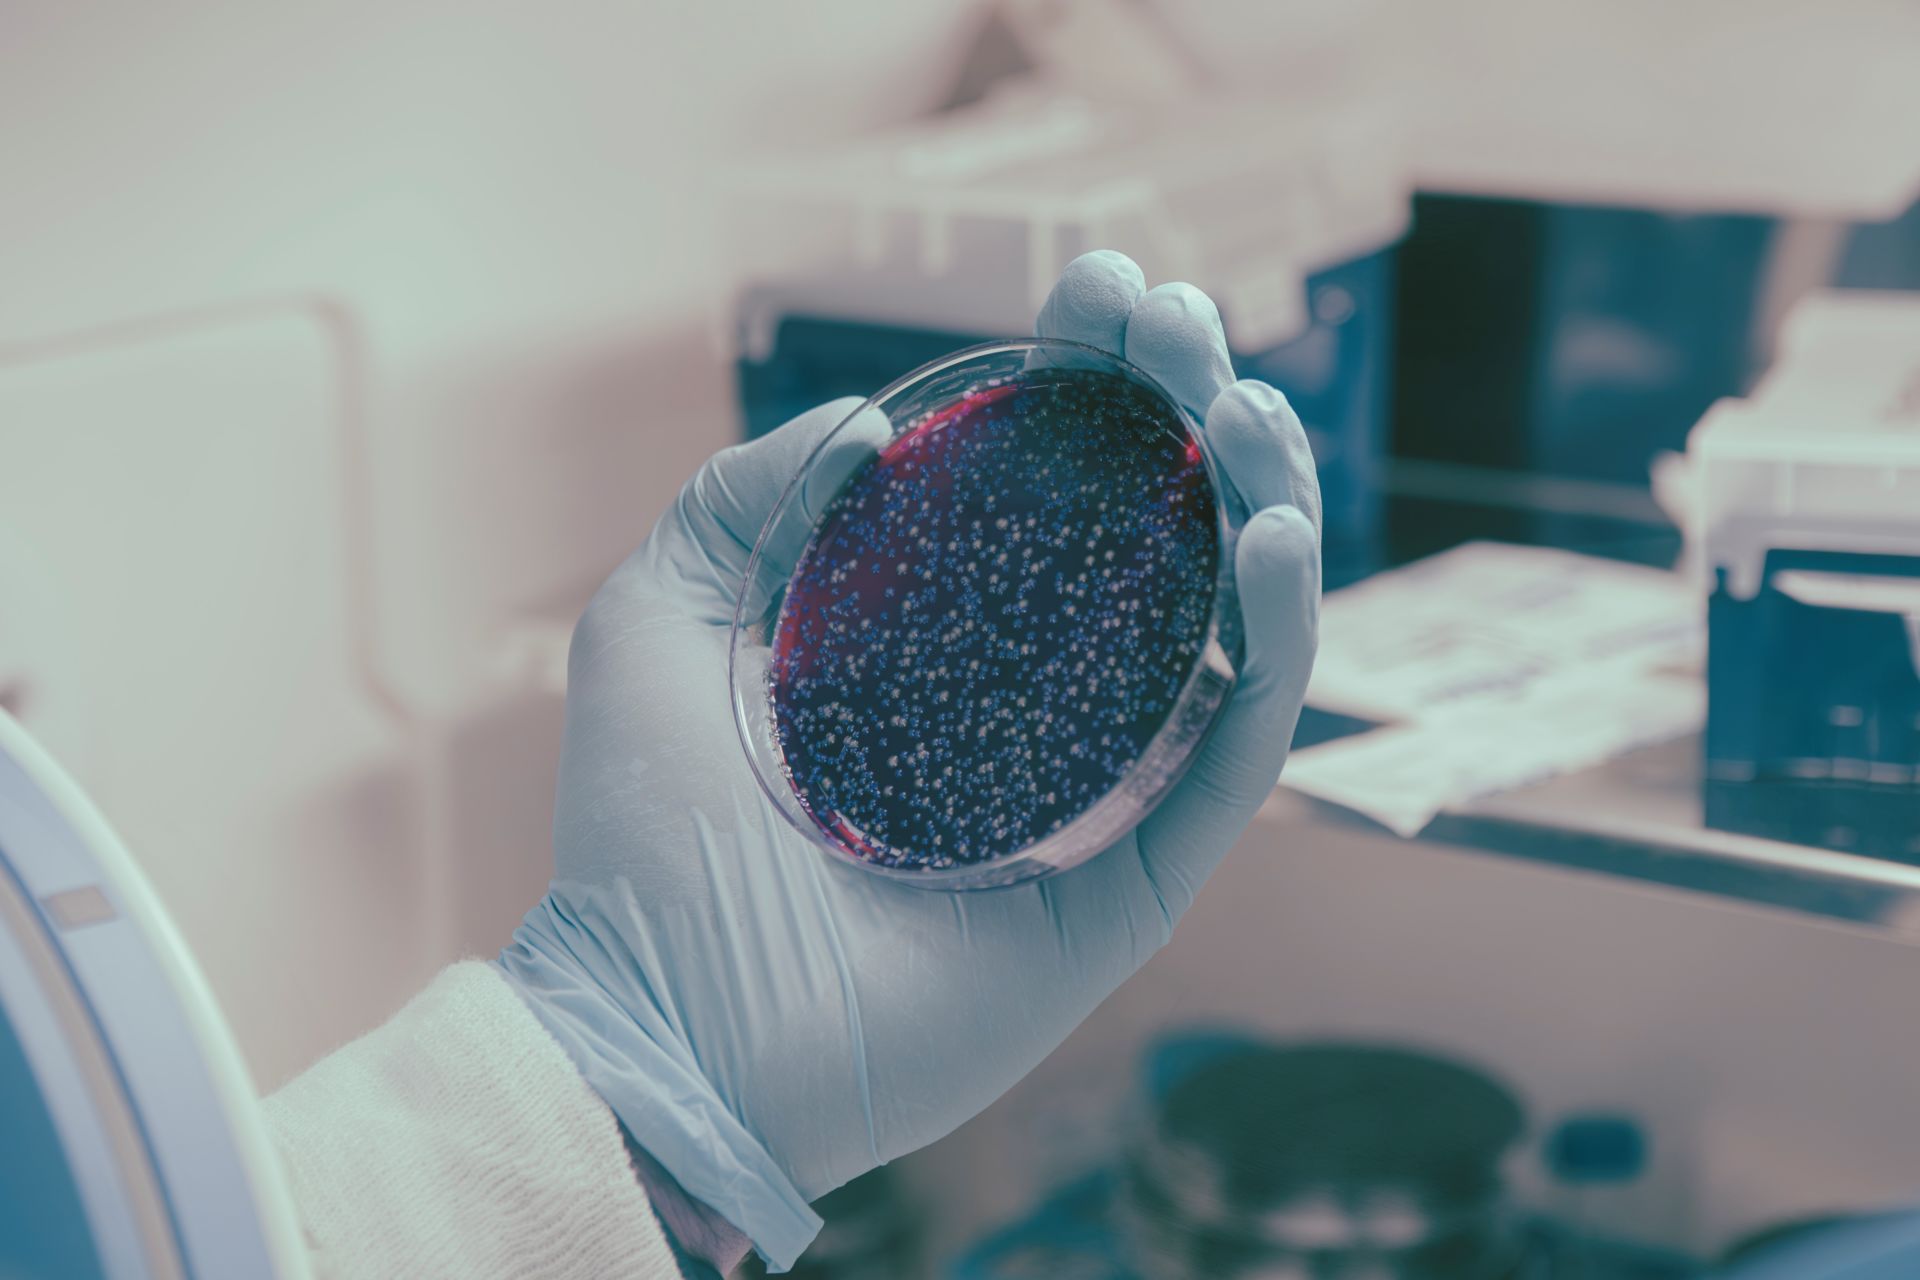

Dalla Ricerca sul microbiota arrivano nuove speranze per migliorare l’efficacia dell’immunoterapia. Secondo i risultati di uno studio guidato dalla prof.ssa Maria Rescigno, Responsabile del Laboratorio di Immunologia delle Mucose e Microbiota di IRCCS Istituto Clinico Humanitas e Prorettrice alla Ricerca di Humanitas University, un particolare ceppo di batteri intestinali è in grado di potenziare l’effetto dell’immunoterapia. I dati ottenuti sono stati pubblicati sulla rivista Cancer Cell.
L’efficacia di queste terapie è infatti limitata dalla capacità del sistema immunitario di riconoscere le cellule tumorali. Sebbene questi farmaci rendano i linfociti T più aggressivi contro il tumore, il loro effetto può essere ridotto o addirittura annullato se le cellule del tumore riescono a nascondersi, per esempio eliminando dalla propria superficie i recettori che le identificano.
«Il Lactobacillus paracasei, uno dei ceppi batterici del microbiota intestinale – spiega la prof.ssa Rescigno – si è dimostrato capace di indurre le cellule tumorali a mostrare i propri recettori e tornare così “visibili” al sistema immunitario. Il meccanismo è mediato da alcuni postbiotici, sostanze prodotte dal metabolismo dei batteri». I ricercatori hanno dimostrato, in alcuni modelli sperimentali di tumore del colon-retto e del seno, che se questi postbiotici sono somministrati insieme ai farmaci immunoterapici, sono in grado di potenziarne l’efficacia.
I risultati della ricerca, anche se per ora limitati a un contesto preclinico, aprono la strada a nuovi approcci terapeutici basati sulla combinazione tra farmaci immunoterapici già approvati in clinica e postbiotici. Lo studio è stato possibile anche grazie al sostegno di Fondazione AIRC per la ricerca sul cancro e di Alan Ghitis Association.

Come il microbiota influenza l’efficacia delle terapie
Risultati di studi recenti hanno mostrato la capacità del microbiota intestinale di influenzare la risposta ad alcune terapie contro il cancro, tra cui le immunoterapie. Nel caso del melanoma e di altri tumori di origine epiteliale, per esempio, diversi studi suggeriscono come la composizione del microbiota possa aumentare l’efficacia del trattamento.
Ma perché il microbiota influenza l’effetto delle immunoterapie? E come utilizzare queste conoscenze per potenziare le terapie a disposizione e il numero di persone che possono giovarne? Per trovare una risposta, il gruppo guidato da Maria Rescigno si è concentrato sulle molecole prodotte dai batteri, i cosiddetti postbiotici.
«L’interesse verso i postbiotici è dovuto a due aspetti fondamentali – spiega Maria Rescigno -. Il primo è loro capacità di attraversare la barriera vascolare intestinale e quindi di influenzare in modo sistemico l’organismo attraverso il sangue, di fatto mediando l’azione a distanza del microbiota intestinale in altre aree del corpo; e la seconda è che costituiscono uno strumento terapeutico più preciso e potente: invece di trapiantare o modificare il microbiota – come viene fatto in alcuni studi – si agisce a valle, somministrando direttamente e solo i prodotti metabolici benefici, a volte comuni a più ceppi batterici che producono però anche sostanze non di interesse terapeutico».
I postbiotici che smascherano le cellule tumorali
Si chiama Lactobacillus paracasei il ceppo batterico identificato dai ricercatori di Humanitas, già noto per le sue proprietà anti-infiammatorie. Secondo i risultati pubblicati su Cancer Cell, i postbiotici prodotti da questo ceppo sono in grado di smascherare le cellule tumorali perché le costringono a mostrare dei recettori, chiamati HLA, senza i quali il sistema immunitario non può riconoscerle.
«Il silenziamento dei recettori HLA, che permette ai tumori di sfuggire al sistema immunitario, è un meccanismo ben conosciuto e descritto in molti tipi di cancro, tra cui il melanoma, il tumore del seno, del colon-retto, dei polmoni e della vescica» – spiega Valentina Ferrari, oggi all’IRB di Bellinzona e prima autrice dell’articolo. Il suo lavoro su questo studio in Humanitas è stato possibile grazie a una borsa di ricerca della Alan Ghitis Assocation.
Questa è però la prima volta che viene dimostrata la capacità dei postbiotici – e quindi del microbiota – di influenzare l’espressione di HLA sulle cellule tumorali e di rendere il tumore più riconoscibile da parte dei linfociti T. I ricercatori hanno anche dimostrato, in modelli sperimentali di cancro del colon-retto e del seno, che l’aggiunta di questi specifici postbiotici agli inibitori dei checkpoint immunitari è in grado di contrastare la crescita del tumore con maggiore efficacia, di fatto potenziando l’immunoterapia. «Nonostante conosciamo da decenni il meccanismo tumorale di elusione della risposta immunitaria tramite la soppressione dei recettori HLA, prima d’ora non si era mai riusciti a trovare un rimedio sicuro ed efficace. Ecco perché il risultato ottenuto è così significativo, anche se per ora i risultati ottenuti sono limitati a esperimenti di laboratorio – conclude la prof.ssa Rescigno –. Il prossimo passo sarà avviare una sperimentazione clinica per verificare se l’approccio può costituire una nuova ed efficace strategia terapeutica per i pazienti che non rispondono alle immunoterapie».
-
2.3 milioni visite
-
+56.000 pazienti PS
-
+3.000 dipendenti
-
45.000 pazienti ricoverati
-
800 medici